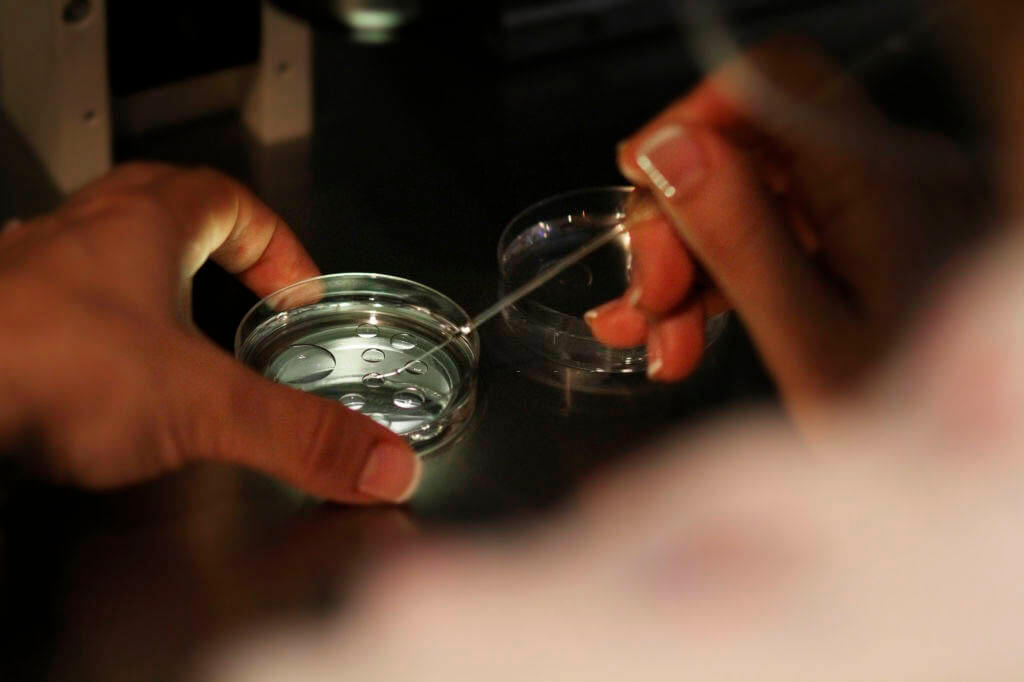
test-cribado-prenatal-img

El test de cribado prenatal no invasivo permite identificar en sangre materna las trisomías fetales de los cromosomas 21 (síndrome de Down), 18 (síndrome de Edwards) y 13 (síndrome de Patau), con una eficacia cercana al 100%. Además, informa sobre el sexo fetal y las aneuploidías de los cromosomas sexuales (Triple X, Doble Y, síndromes de Turner y Klinefelter).
Incidencias y consecuencias de estos síndromes en pacientes
El síndrome de Down es una anomalía genética causada por la presencia de un tercer cromosoma 21. Los pacientes presentan unas características morfológicas determinadas, discapacidad intelectual y otras complicaciones como defectos cardíacos congénitos y leucemia. La incidencia del síndrome de Down es de aproximadamente 1 de cada 700 nacimientos. Esta se incrementa con la edad materna en el embarazo, siendo de 1 en 1.400 nacimientos por de bajo de los 25 años. A la edad de 35 es de 1 cada 350 y 1 cada 100 a la edad de 40 años.
Las trisomías 13 y 18 son menos frecuentes, siendo la incidencia 1 de cada 5.000 nacimientos. Causan enfermedades muy graves y presentan un elevado índice de abortos espontáneos.
¿Por qué deberíamos realizar el test de cribado prenatal no invasivo?
Al ser un test no invasivo, no hay riesgo de infección intrauterina ni de abortos espontáneos. Se realiza a partir de sangre periférica materna donde se encuentra ADN fetal circulante. Es la mejor alternativa cuando las pruebas invasivas como la amniocentesis no son una opción.
Existe también la posibilidad de descartar síndromes genéticos que tienen su origen en la pérdida o ganancia de pequeñas porciones del genoma, denominados síndromes de microdeleción y microduplicación. Estos síndromes causan en los bebés afectos problemas de salud al nacimiento, que incluyen malformaciones en diversos órganos y discapacidad intelectual. No están relacionados con la edad materna.
El test de cribado prenatal no invasivo permite una detección precoz de estos síndromes, pudiendo realizarse a partir de la décima semana de gestación (primer trimestre del embarazo).
Para su realización sólo se necesitan 10 ml de sangre materna.
Se puede utilizar en embarazos gemelares y en mujeres receptoras de ovocitos.
Interpretaciones de los resultados obtenidos
Los resultados obtenidos se pueden clasificar principalmente en 2 grupos:
- Bajo Riesgo: Con una especificidad cercana al 100 % el bebé no va a presentar Síndrome de Down, ni las otras trisomías analizadas.
- Alto Riesgo: En este caso el resultado debe ser confirmado por una técnica genética invasiva sin coste adicional. Amniocentesis + QF-PCR.
Para recibir más información acerca del test de cribado prenatal no invasivo, puedes ponerte en contacto con nosotros en nuestra consulta o dirigirte directamente al Dr. Juan Menaya llamando al (+34) 658 91 82 79 o escribiendo a jmenaya@centrodeestudiosgeneticos.es
El Dr. Juan Menaya, doctor especialista en genética molecular, también realiza test COVID, PCR, tests de serología y detección de antígenos en su consulta.